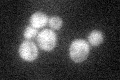
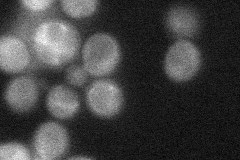
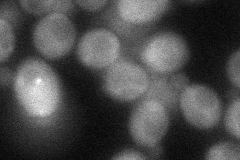

View description
One of two (see also PSK1) PAS domain containing S/T protein kinases; regulates sugar flux and translation in response to an unknown metabolite by phosphorylating Ugp1p and Gsy2p (sugar flux) and Caf20p, Tif11p and Sro9p (translation)
Localization:
Intensity:
Fold change:
Significance:
-
C’ GFP library in SD
cytosol25.97 -
N' NOP1pr-GFP in SD

cytosol50.0134 -
N' TEF2pr-mCherry in SD

cytosol69.6424 -
N' NATIVEpr-GFP in SD
cytosol33.9857 -
N' TEF2pr-VC and Cyto-VN in SD
cytosol43.5641 -
C’ GFP library in SD+DTT

cytosol24.860.95No -
C’ GFP library in SD+H2O2

cytosol26.711.02No -
C’ GFP library in Starvation Media

cytosol17.560.67No -
C’ GFP library on the background of Pup2-DaMP

cytosol -
C’ GFP library on the background of CCT mutant

cytosol29.61521.14013No
